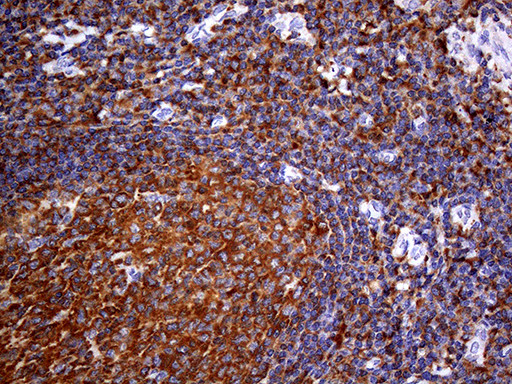
FERMT3 Antibody in Immunohistochemistry (Paraffin) (IHC (P))

Search
OriGene
FERMT3 Monoclonal Antibody (OTI2H10), TrueMAB™
{{$productOrderCtrl.translations['antibody.pdp.commerceCard.promotion.promotions']}}
{{$productOrderCtrl.translations['antibody.pdp.commerceCard.promotion.viewpromo']}}
{{$productOrderCtrl.translations['antibody.pdp.commerceCard.promotion.promocode']}}: {{promo.promoCode}} {{promo.promoTitle}} {{promo.promoDescription}}. {{$productOrderCtrl.translations['antibody.pdp.commerceCard.promotion.learnmore']}}
产品信息
TA807993
种属反应
宿主/亚型
分类
类型
克隆号
抗原
偶联物
形式
浓度
纯化类型
保存液
内含物
保存条件
运输条件
靶标信息
The three KINDLINs are a novel family of focal adhesion proteins, localizing to integrin adhesion sites. The KINDLIN proteins are composed of a centrally located FERM domain interrupted by a pleckstrin homology (PH) domain. KINDLIN1 and KINDLIN2 have been shown to play an essential role in integrin-mediated adhesion and spreading. In contrast to the widely expressed KINDLIN1 and KINDLIN2, KINDLIN3 is restricted to hematopoietic cells and is particularly abundant in megakaryocytes and platelets. Several reports describe a transcriptional misregulation of KINDLINs in various types of cancer. A recent study demonstrates that KINDLIN3 is essential for platelet integrin activation and subsequent integrin outside-in signaling, suggesting it may serve as a potential target for the design of therapeutics aimed at specifically disrupting integrin activation in platelets and leukocytes.
仅用于科研。不用于诊断过程。未经明确授权不得转售。
篇参考文献 (0)
生物信息学
蛋白别名: Fermitin family homolog 3; kindlin 3; Kindlin-3; MGC10966; MIG2-like protein; UNC-112 related protein 2; Unc-112-related protein 2
基因别名: FERMT3; KIND3; MIG-2; MIG2B; UNC112C; URP2; URP2SF
UniProt ID: (Human) Q86UX7
Entrez Gene ID: (Human) 83706